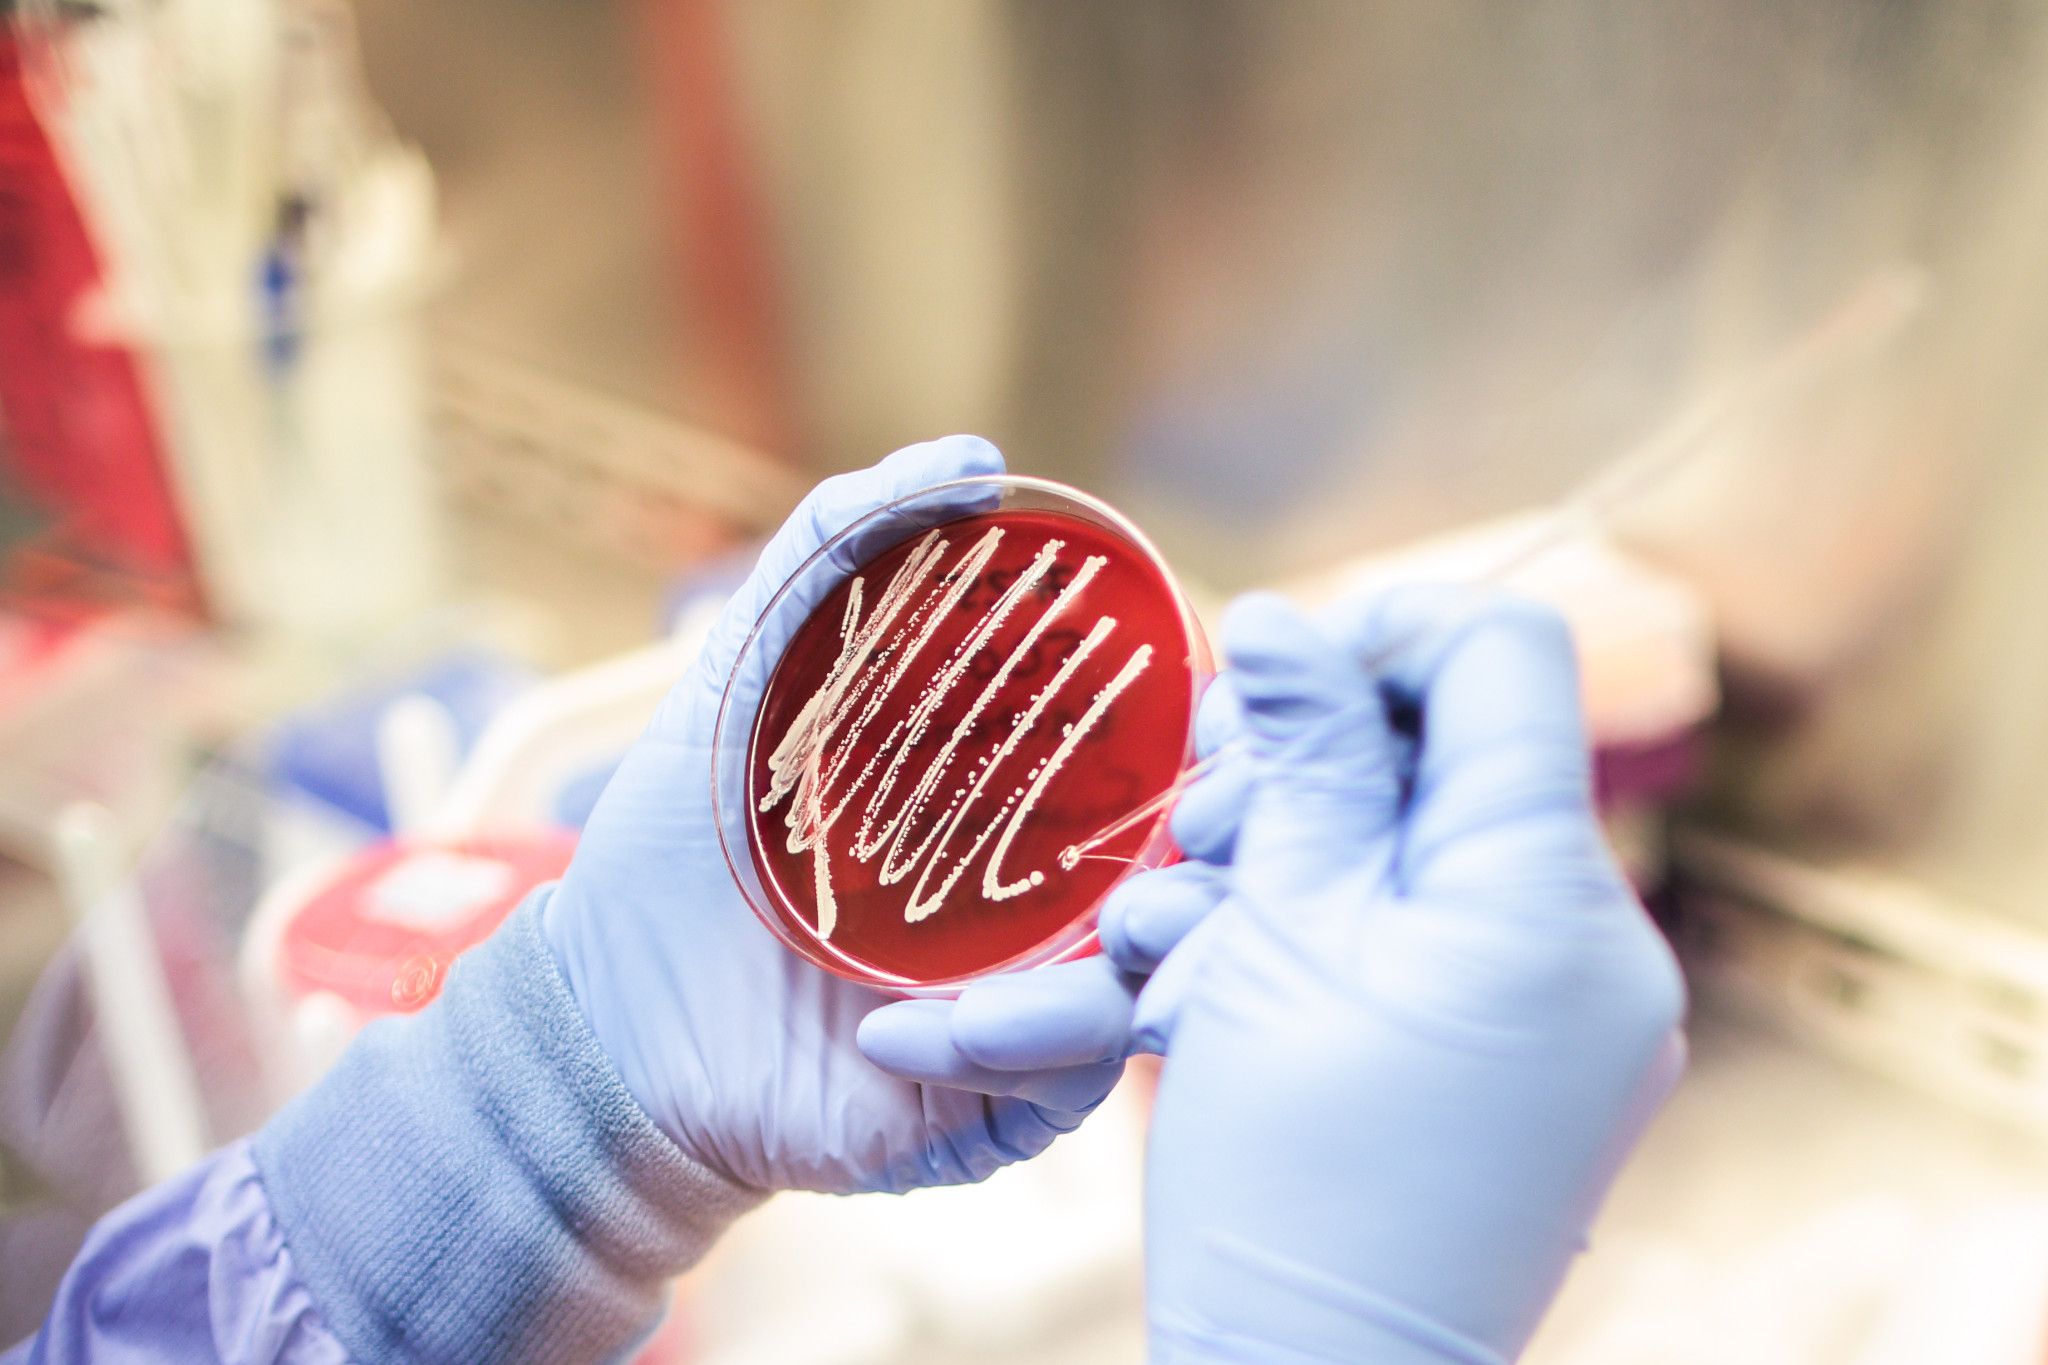
Accugenix® Microbial Identification & Strain Typing

Charles River’s Accugenix® microbial ID and strain typing services offer unparalleled accuracy with the most relevant reference libraries of bacteria, filamentous fungi, and yeasts. We’ve driven the development and adoption of the most progressive technologies to improve our clients’ environmental monitoring, reduce their costs, and protect their brands. Our flexible solutions allow clients to outsource to our experts or use our services in-house.
Accurate identification of environmental isolates improves reporting capabilities, facilitating full investigation of root causes for contamination and informed decision-making. With accurate data, it is possible to fully understand issues that arise and develop an appropriate plan to reduce production recovery time and minimize the impact to the supply chain cycle.
The Accugenix® Libraries
The industry’s most comprehensive and up-to-date databases for environmental isolates, our Accugenix® reference libraries contain more than 14,000 entries for bacteria, filamentous fungi, yeast, and other relevant isolates found in today’s manufacturing environments. As we continue to partner with clients to identify unknown samples, our databases continue to grow, making Accugenix® unmatched for breadth and accuracy.

AccuGENX-ID® (genotypic) Microbial Sequencing
Comparative DNA sequencing of the 16S rRNA gene in bacteria and the ITS2 rRNA region in fungi is recognized across the industry as the most accurate and reproducible method for identifying unknown microorganisms. AccuGENX-ID® utilizes this technology through our BacSeq identification for bacteria and FunITS identification for fungi. Our sequencing technique is independent of the health or growth conditions of the isolate; samples can be viable or nonviable cultures or simply genomic DNA from a microbe. For each sample submitted for identification, the resulting DNA sequence is compared against our validated libraries for bacteria and fungi.
AccuGENX-ID® is the ideal solution for aseptic-filled products, cleanrooms, bioburden, and contamination investigations, achieving maximum accuracy with minimum hassle and delivering rapid and reproducible results in as little as six hours.
AccuGENX-ID® bacteria (16S 500bp)
BacSeq-0,1,2,5
AccuGENX-ID® fungi (ITS2)
FunITS-0,1,2,5
AccuGENX-ID® ProSeq
PROSEQ-1,5

AccuPro-ID® (proteotypic) MALDI-TOF Microbial Identification
Offers a first-in-industry polyphasic approach to microbial identifications. As the earliest contract laboratory to adopt MALDI-TOF technology for identification of bacteria, we offer an industry-leading MALDI-TOF library that is focused on bacteria and yeast relevant to production environments. This extensive library is backed up by our AccuGENX-ID®16S and ITS2 rDNA sequencing method at no additional cost. Providing higher accuracy rates and faster results, AccuPro-ID® is a less expensive option for environmental monitoring programs. The service is both an attractive alternative to the genotypic service and far superior to antiquated biochemical identification systems.
AccuPro-ID® bacteria and yeast
AccuPRO-ID-0,1,2,5

AccuBlast® Sequencing Data Analysis
AccuBlast® service is designed exclusively for customers who have purchased the MicroSEQ® identification system and are not confident in the identifications made by the automated system. The AccuBlast® service employs Charles River unrivaled sequence libraries and expert data analysis to generate meaningful reports, allowing us to deliver IDs more quickly and accurately.
AccuBlast® analysis of 16S raw data sequences files
AccuBLAST-0,1,2
AccuGENX-ST® (strain typing)
SLST and MLST with AccuGENX-ST®
In addition to sequence-based microbial identification service, Charles River offer strain typing by single or multilocus sequence typing (SLST or MLST), both of which are sequence-based strain typing methods. It is DNA sequencing of targets outside of the standard regions sequenced for microbial identification (16S, D2, or ITS2) to provide you with data to prove differences and/or similarities at the strain level. When production facilities experience microbial contamination, it becomes a priority to identify the source. Using AccuGENX-ST® strain typing helps microbiologists in investigations of microbial contamination in production facilities.
AccuGENX-ST® sequence-based strain typing
AccuGENX-ST-5
AccuGENX-ST® multi-locus sequence-based strain typing
AccuGENX-XGST-5

Do you have a question about this product?


